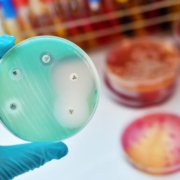

Μελέτη: Πάνω από 1 εκατ. άνθρωποι πέθαναν το 2019 από αντιμικροβιακή αντοχή
Οι ανθεκτικές στα αντιβιοτικά βακτηριακές λοιμώξεις προκάλεσαν περίπου 1,2 εκατομμύρια θανάτους το 2019 παγκοσμίως, σύμφωνα με νέα έρευνα που δημοσιεύθηκε την Τετάρτη (19 Ιανουαρίου). Οι επιστήμονες ζητούν περισσότερες επενδύσεις και καλύτερη χρήση των υφιστάμενων αντιβιοτικών.
Η ανάλυση των παγκόσμιων επιπτώσεων της μικροβιακής αντοχής (AMR), που δημοσιεύθηκε στο ιατρικό περιοδικό «The Lancet», αποκάλυψε ότι η AMR προκάλεσε πάνω από 1,2 εκατομμύρια θανάτους το 2019. Επιπλέον, οι λοιμώξεις ανθεκτικές στα αντιμικροβιακά έπαιξαν ρόλο σε σχεδόν 5 εκατομμύρια θανάτους.
«Προηγούμενες εκτιμήσεις είχαν προβλέψει 10 εκατομμύρια ετήσιους θανάτους από μικροβιακή αντοχή έως το 2050, αλλά τώρα γνωρίζουμε με βεβαιότητα ότι βρισκόμαστε ήδη πολύ πιο κοντά σε αυτό το ποσοστό από ό,τι πιστεύαμε», δήλωσε ο συν-συγγραφέας της μελέτης καθηγητής Chris Murray, του Ινστιτούτου Μετρήσεων και Αξιολόγησης της Υγείας στο Πανεπιστήμιο της Ουάσιγκτον.
Τα ευρήματα αυτά αποκάλυψαν ότι «η ανθεκτικότητα στην ανθεκτικότητα είναι πλέον η κύρια αιτία θανάτου παγκοσμίως, υψηλότερη από το HIV/AIDS ή την ελονοσία», σύμφωνα με δήλωση τύπου του «The Lancet». Το HIV/AIDS και η ελονοσία εκτιμάται ότι προκάλεσαν 860.000 και 640.000 θανάτους, αντίστοιχα, το 2019.
Ο Ramanan Laxminarayan από το «Center for Disease Dynamics», ο οποίος δεν συμμετείχε στη μελέτη, υπογράμμισε ότι ο HIV προσελκύει σχεδόν 44 δισεκατομμύρια ευρώ ετησίως σε χρηματοδότηση της έρευνας. «Ωστόσο, οι παγκόσμιες δαπάνες για την αντιμετώπιση της ΑΜΡ είναι πιθανώς πολύ χαμηλότερες από αυτό».
Η κακή και υπερβολική χρήση αντιβιοτικών τα τελευταία χρόνια έχει οδηγήσει ορισμένα βακτήρια στην ανάπτυξη μικροβιακής αντοχής, πράγμα που σημαίνει ότι τα αντιβιοτικά γίνονται λιγότερο αποτελεσματικά και οι λοιμώξεις επιμένουν στον οργανισμό.
Αυτό σημαίνει ότι οι προηγουμένως θεραπεύσιμες λοιμώξεις – όπως οι λοιμώξεις του κατώτερου αναπνευστικού ή της κυκλοφορίας του αίματος – γίνονται πλέον θανατηφόρες για χιλιάδες ανθρώπους λόγω της ανθεκτικότητας των βακτηρίων στη θεραπεία.
Η μελέτη εξέτασε 23 οργανισμούς που προκαλούν ασθένειες, από τους οποίους η ανθεκτικότητα στα φάρμακα μόνο σε έξι βακτήρια οδήγησε άμεσα σε σχεδόν 930.000 θανάτους και ενώ συνολικά συσχετίστηκε με πάνω από 3,5 εκατομμύρια θανάτους. Η ανθεκτικότητα στις φθοριοκινολόνες και στα αντιβιοτικά β-λακτάμης, όπως οι πενικιλίνες, – τα οποία συχνά θεωρούνται η «πρώτη γραμμή» άμυνας κατά των σοβαρών λοιμώξεων, ευθύνεται για πάνω από το 70% των θανάτων που αποδίδονται στην ΑΜΡ, σύμφωνα με τη μελέτη.
Ο Murray δήλωσε ότι τα νέα αυτά δεδομένα αποτελούν «σαφές μήνυμα ότι πρέπει να δράσουμε τώρα για να καταπολεμήσουμε την απειλή».
Για να αντιμετωπιστεί αυτό, οι ερευνητές ζήτησαν την κλιμάκωση της δράσης για την καταπολέμηση της ΑΜΡ με τη βελτίωση των μέτρων ελέγχου των λοιμώξεων, τη βελτιστοποίηση της χρήσης των υφιστάμενων αντιβιοτικών και την παροχή περισσότερης χρηματοδότησης για την ανάπτυξη νέων αντιβιοτικών και θεραπειών.
«Πρέπει να αξιοποιήσουμε αυτά τα δεδομένα για να διορθώσουμε την πορεία της δράσης και να προωθήσουμε την καινοτομία, αν θέλουμε να παραμείνουμε μπροστά στον αγώνα κατά της μικροβιακής αντοχής», δήλωσε ο Murray.
Διαφορές ανά τον κόσμο
Η μελέτη διαπίστωσε ότι το υψηλότερο ποσοστό θανάτων σε όλες τις ηλικίες που αποδίδονται και σχετίζονται με τη μικροβιακή αντοχή ήταν σε περιοχές της Αφρικής. Εξετάζοντας την Ευρώπη, οι περισσότεροι θάνατοι καταγράφηκαν στο ανατολικό τμήμα, ενώ οι λιγότεροι στη δυτική.
«Με την ανθεκτικότητα να διαφέρει τόσο σημαντικά ανά χώρα και περιοχή, η βελτίωση της συλλογής δεδομένων παγκοσμίως είναι απαραίτητη για να μας βοηθήσει να παρακολουθήσουμε καλύτερα τα επίπεδα ανθεκτικότητας και να εξοπλίσουμε τους κλινικούς γιατρούς και τους υπεύθυνους χάραξης πολιτικής με τις πληροφορίες που χρειάζονται για να αντιμετωπίσουν τις πιο πιεστικές προκλήσεις που θέτει η μικροβιακή αντοχή», δήλωσε η συν-συγγραφέας της μελέτης καθηγήτρια Christiane Dolecek.
Η μελέτη τόνισε ότι οι χώρες χαμηλού και μεσαίου εισοδήματος επηρεάζονται περισσότερο, αν και οι χώρες υψηλότερου εισοδήματος αντιμετωπίζουν επίσης ανησυχητικά υψηλά επίπεδα ΑΜΡ.
«Εντοπίσαμε σοβαρά κενά δεδομένων σε πολλές χώρες χαμηλού εισοδήματος, υπογραμμίζοντας την ιδιαίτερη ανάγκη για αύξηση της εργαστηριακής ικανότητας και της συλλογής δεδομένων σε αυτές τις περιοχές», δήλωσε η Dolecek.
Η μελέτη έδειξε επίσης ότι τα μικρά παιδιά διατρέχουν τον υψηλότερο κίνδυνο μεταξύ όλων των ηλικιακών ομάδων. Περίπου ένας στους πέντε θανάτους που αποδίδονται στην ΑΜΡ συνέβη σε παιδιά ηλικίας κάτω των πέντε ετών.
Η Επίτροπος Υγείας της Ευρωπαϊκής Επιτροπής, Στέλλα Κυριακίδου, αναγνώρισε την απειλή που συνιστά η ΑΜΡ, λέγοντας ότι η Κομισιόν σχεδιάζει μια σειρά μέτρων για την αντιμετώπισή της. Συγκεκριμένα δήλωσε τα εξής: «Η στρατηγική μας «Farm to Fork» επιδιώκει να μειώσει στο μισό τις πωλήσεις αντιμικροβιακών ουσιών στην ΕΕ για τα εκτρεφόμενα ζώα και την οπισθοδρομική καλλιέργεια έως το 2030».
πηγή: euractiv.gr